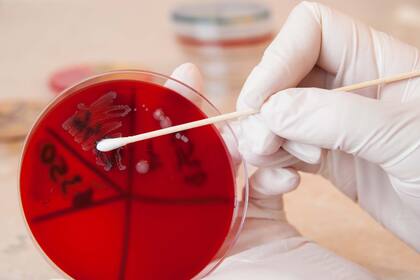
Laboratorio; Meningitis; vacuna; enfermedad; Salud; Sociedad

Alerta meningitis: por la baja cobertura de vacunación, se duplicaron los casos en 2022
La advertencia fue notificada en el Boletín Epidemiológico Nacional difundido por el Ministerio de Salud; la tasa de muertes por esta afección del último bienio fueron las más altas de los últimos 5 años
5 minutos de lectura'
El número de casos notificados de meningitis se incrementó en 2022 en más del doble respecto de los registrados en el año 2020 y en 2021, cuando en cada uno de esos periodos se dio la menor cantidad de cotagios de la última década. No obstante, el aumento es un 27% mayor que el notificado en 2019, previo a la pandemia por coronavirus. Esto se debe a “las bajas coberturas de vacunación registradas en los últimos años”, según se informó en el Boletín Epidemiológico Nacional.
La meningitis por meningococo es una enfermedad del sistema nervioso central (SNC) que consiste en la inflamación de las meninges (que de agravarse puede afectar el encéfalo y más estructuras adyacentes) y se contagia a través de gotitas que salen de la nariz o la boca cada vez que una persona infectada tose o estornuda.
La meningitis es fácilmente mal diagnosticada dado que sus síntomas tempranos (fiebre, irritabilidad, dolor de cabeza, vómitos, diarrea) se asemejan a otras enfermedades comunes y puede llevar a la muerte de 24 a 48 horas. Según datos del Instituto Malbrán, en el 2018, el 68% de los casos en menores de 5 años fueron causados por la meningitis serogrupo B.
De acuerdo con el informe difundido esta semana, las bajas en los contagios que se dieron desde 2010 se debieron a la introducción de una nueva vacuna en el Calendario Nacional de Vacunación y a que la cobertura, o vacunación efectiva fue amplia.
“En el período 2010-2022 se registraron entre 50 y 230 casos anuales de meningitis neumocócica en la población general, con tasas de incidencia entre 0,12 y 0,55 cada 100.000 habitantes, evidenciándose una tendencia decreciente a partir del año 2012, luego de la introducción de la vacuna conjugada 13-valente (PCV-13) al Calendario Nacional de Vacunación”, comienza el informe sobre esta enfermedad inmunoprevenible.
La reducción en el número de casos en esa década “se relaciona fundamentalmente a la disminución de casos en el grupo etario de menores de 5 años, grupo elegible para la vacunación por calendario y sobre el cual se identificaba la mayor carga de enfermedad”.

Sin embargo, en 2022 “se evidenció un aumento en el número de casos de meningitis neumocócica en la mayoría de los grupos etarios respecto de los datos obtenidos en los últimos años”, más del doble respecto de los registrados cada año en el bienio 2020-2021 y en un 27% más que los notificados en 2019.
En cuanto a la distribución, se notificaron casos en 21 de las 24 provincias. La mayor cantidad, el 67% de las notificaciones, se concentraron en las provincias de Buenos Aires, Ciudad de Buenos Aires, Chaco, Córdoba y Santa Fe.
Las provincias de La Pampa, Chaco y Tierra del Fuego presentaron las más altas tasas de incidencia, es decir, se presentó la mayor cantidad de nuevos casos en un período de tiempo y en una población específica. Así, la tasa de incidencia superó valores de 1 cada 100.000 habitantes.
Muertes por meningitis debido a la baja vacunación
De acuerdo con el informe, las tasas de letalidad por meningitis neumocócica del último bienio fueron las más altas de los últimos 5 años ya que se registró una letalidad de 9,9% con 14 fallecimientos notificados por esta causa en 2022.
En el Boletín Epidemiológico Nacional se concluyó que “las bajas coberturas de vacunación registradas en los últimos años generaron un cúmulo de susceptibles que favorece la reemergencia y aparición de brotes por esta enfermedad”.
Esta inflamación meníngea puede obedecer tanto a causas infecciosas como a causas no infecciosas, “aunque las etiologías infecciosas (particularmente las infecciones bacterianas y virales) son las más frecuentes y las más importantes desde la perspectiva de la salud pública, no sólo por la magnitud de casos ocurridos anualmente, sino también por su potencial para producir brotes”, se recordó en el Boletín.
Las infecciones causadas por Streptococcus pneumoniae (neumococo), Haemophilus influenzae tipo b y Neisseria meningitidis (meningococo) “han sido las responsables de la mayoría de los casos de meningitis bacterianas agudas en la era pre-vacunación”, señala el informe.
Además, destaca que “la incidencia en la infección invasiva por estos gérmenes ha disminuido significativamente en los últimos años y luego de la introducción de sus respectivas vacunas al Calendario Nacional”.
Como la bacteria se refugia en la mucosa respiratoria (principalmente en la boca y la nariz), se transmite fácilmente al hablar, toser, estornudar o besar a otra persona.
Según distintos estudios, dos de cada diez personas son portadoras sanas del meningococo hasta 6 meses y pueden transmitirla sin desarrollar ninguna enfermedad. Pero quien tiene contacto cercano con ese portador tiene hasta 800 veces más riesgo de adquirir la bacteria y, a la vez, transmitirla o desarrollar la enfermedad.
Otras noticias de Salud
Tras siete años de distanciamiento. Meghan Markle se acercó a su padre, quien atraviesa un duro momento de salud
Tips. Qué implica “dormir bien” y por qué a algunas personas les cuesta lograr un sueño reparador
Difícil performance. El incómodo momento de Robbie Williams durante el sorteo del Mundial 2026
1Del sueño europeo a la incertidumbre: la familia argentina que quedó atrapada por un cambio de las leyes migratorias
- 2
Bajo Belgrano: el gobierno nacional subastará una manzana y hay inquietud en los vecinos
3Pantallas: un país de la región será el pionero en prohibir los celulares en todas las escuelas y el debate no deja de crecer
- 4
Hay alerta naranja y amarilla por tormentas y calor extremo para este viernes 5 de diciembre: las provincias afectadas







